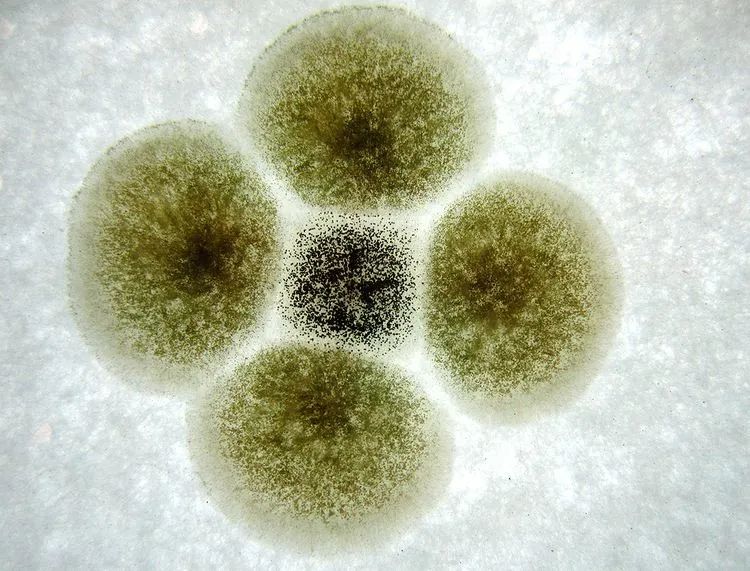

一、常见的食品微生物指标
1
霉 菌
霉菌是形成分枝菌丝的真菌的统称,并非分类学的名词,在分类上属于真菌门的各个亚门。霉菌有着极强的繁殖能力,并会产生生物毒素,不同种类的霉菌其生长繁殖的速度和产毒的能力有差异,霉菌毒素中毒性较强的有黄曲霉毒素、赭曲霉毒素等。
最常见的黄曲霉毒素有很强毒性,属于一类致癌物,食用被黄曲霉毒素污染的食品可能导致急性中毒,引起肝脏坏死出血,甚至导致死亡。正因如此,它还差点在2020年“酸汤子”事件中替米酵菌酸背上致死9人的锅。
2
酵 母 菌

酵母是一种单细胞真菌,属于兼性厌氧菌。在食品工业运用中十分广泛,常见用于发面、酿酒、酸奶制作等等。酵母菌超标会引起食物过度发酵导致腐败变质,食用酵母超标的食物容易引起腹泻,危害人体健康。
此外,酵母菌还是评价食品卫生质量的指标之一,例如近期上海市场监管部门抽检的某品牌酸奶酵母超标60倍,反映出可能存在加工用原料受污染,或是产品存储、运输条件控制不当的问题。糕点、奶制品及饮料等食品是酵母菌最常污染的食品种类。
3
大 肠 菌 群

大肠菌群主要包括肠杆菌科中埃希氏菌属、柠檬酸杆菌属、魔雷伯氏菌属和肠杆菌属,其中大肠埃希氏菌、沙门氏菌都是常见的致病菌。大肠菌群被我国和许多其他国家广泛用作食品卫生质量检验的指示菌,反映食品被粪便污染的情况。
粪便内除一般正常细菌外,同时也会有一些肠道致病菌存在(如沙门氏菌、志贺氏菌等),食用受到致病菌污染的食物可能引发食源性疾病。如引发全球关注的欧洲“毒黄瓜”事件,就是由受肠出血性大肠杆菌(EHEC)“污染”的黄瓜引发致命性的溶血性尿毒症,导致16人死亡,上千人感染。
4
菌 落 总 数

菌落总数是指在一定条件下(如需氧情况、营养条件、pH、培养温度和时间等)每克(每毫升)检样所生长出来的细菌菌落总数。菌落总数并不表示实际中的所有细菌总数,也并不能区分其中细菌的种类,所以有时被称为杂菌数,需氧菌数等。
菌落总数测定是用来判定食品被细菌污染的程度及卫生质量,它反映食品在生产过程中是否符合卫生要求,以便对被检样品做出适当的卫生学评价。菌落总数的多少在一定程度上标志着食品卫生质量的优劣。
二、如何降低
误食微生物超标食品的风险
● ● ● ● ● ● ●
1
不要食用超过保质期的食品

保质期,通常指预包装食品在标签指明的贮存条件下,保持品质的期限。超过保质期的食品存在食品安全风险。
● ● ● ● ●
2
严格按照贮存条件保存食物
影响微生物生长繁殖及产毒的因素是很多的,密切相关的有水分、温度、通风等条件,为降低微生物繁殖及产毒速度,请严格按照食品标签上的贮存条件进行保存。
● ● ● ● ●
3
食物充分加热后再食用

大多数微生物不耐热,充分加热后可杀死大部分的致病菌。值得一提的是,致病菌产生的生物毒素不一定能被消除,如黄曲霉毒素就可耐200℃的高温,因此发霉食物一定不要食用。
● ● ● ● ●
来源:12360海关热线

